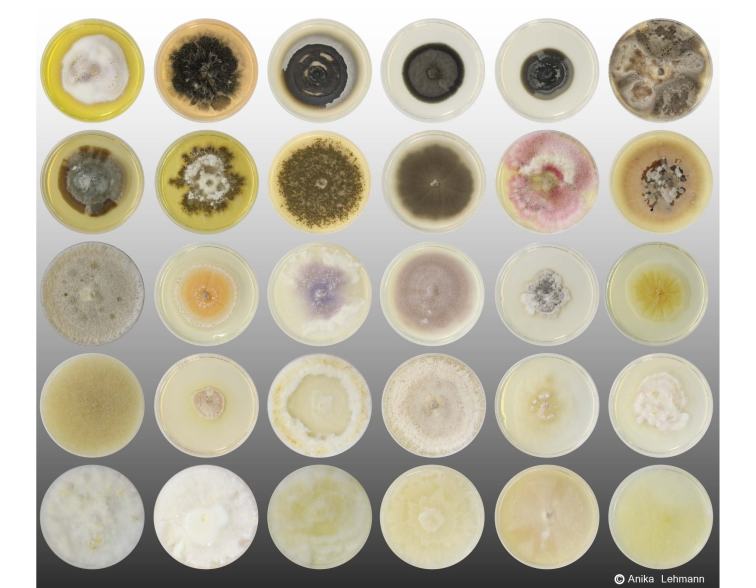

Our podcast Life in the Soil brings you the insights and voices of some of the world’s best soil scientists. Learn about soil biodiversity, why it matters, and how we can protect it.
Subscribe
There’s a hidden world beneath your feet, the world of earthworms, springtails, fungi, and bacteria. We hardly ever see these little creatures, but their impacts are huge.
Episode 1: Living Soil – a Habitat Hidden from View
Soils and their inhabitants play a big role for the overground world, from food security to climate change. It’s a special habitat, full of surprises. In this episode, host Anja Krieger learns more from co-producer Matthias Rillig and soil scientist Johannes Lehmann. Published on World Soil Day, December 5, 2020.

Episode 2: Fungi – the Kingdom of Mushrooms, Spores, and Networks
Hundreds of millions of years ago, plants started to colonize the land. But amazingly, they did this without roots. So how on Earth did these early plants feed themselves? It looks like they found some helpful friends: The so-called mycorrhizal fungi. How does the plant-fungi relationship work? Is it love or just a deal? And how do fungi travel? In this episode, Anja learns more from Katie Field, Toby Kiers, Bala Chaudhary and podcast co-producer Matthias Rillig. Published December 18, 2020.
Episode 3: The Soil Food Web – A Jungle in Tiny Dimensions
In this episode, Anja and Matthias go on an underground safari through the hidden jungle of the soil. We hear from Diana Wall about a tiny worm that is so tough it survives in Antarctica. Richard Bardgett introduces us to collembola, also known as springtails. Stefan Scheu and Maddy Thakur reveal which animals are considered the “wolves of the soil”, and Kate Scow delves into bacterial communities. How do all these organisms work together as a system? Published January 15, 2021. Image by Andy Murray, chaosofdelight.org.

Episode 4: Methods – How to Explore a Microscopic World
If you dig out a handful of soil, what do you see? Really, not that much? That’s one reason the study of soil is such a challenge. It’s a lot of stuff mushed together, crumbs, roots, dead stuff, critters. How do you map that complex landscape and ecosystem? In this episode, scientists share their methods and challenges, and dream of new technology to improve the understanding of soil in major ways – if it just existed! Meet Asmeret Asefaw Berhe, Kate Scow, Marcel van der Heijden and Maddy Thakur. Publication: February 19, 2021.

Episode 5: Soil and Global Change – The Multiple Impacts of Human Action
The list of how humans are causing trouble in the soil is pretty mind-blowing, kind of overwhelming. It’s connected to all that is central to our modern human societies – industrial agriculture, synthetic chemistry, city sprawl, global mobility and so on and on. In this episode, Matthias, Anja and their guests Maddy Thakur and Asmeret Asefaw Berhe explore the human impacts on soil and their cascading effects. Published March 5, 2021.

Episode 6: Sustainability – Healthy Soils, from Farms to Cities
Soil is full of amazing life with its own intrinsic value. Just like many other species, we humans benefit from it: Healthy soil not only provides food, feed, fiber and fuel, it also contributes to the stability of the whole Earth system. But living soils are at risk all around the world. So, in this episode, Anja and Matthias take a look into the sustainable future: How can we, as individuals and societies, nurture and restore the ecosystems of the soil? Hear from Katie Field, Marcel van der Heijden, Bala Chaudhary, Maddy Thakur, Yong-Guan Zhu and Richard Bardgett in the final episode of this mini-series on soil ecology. Published April 1, 2021.

About this project
Our audio podcast series Life in the Soil was produced in collaboration between the Rillig Lab and podcaster Anja Krieger, funded through the BiodivERsA projekt Digging Deeper.
